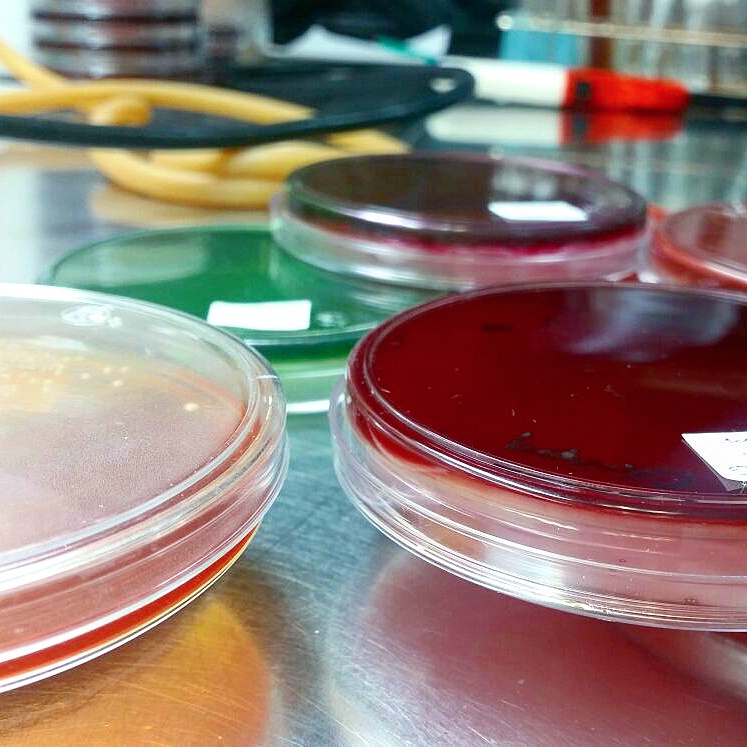

¡Tu carrito está actualmente vacío!
Maestría y Doctorado con orientación en Microbiología médica
El Departamento de Microbiología, a través de la Subdirección de Estudios de Posgrado de la Facultad de Medicina y Hospital Universitario «Dr. José Eleuterio González», ofrece los programas de Maestría y Doctorado en Ciencias a todos los profesiones del área de las ciencias de la salud o afines, con intereses en la formación de una carrera científica en el marco de las ciencias microbiológicas.
Información para aspirantes
Consulta las bases y los planes de estudio para los programas de Maestría y Doctorado en Ciencias con orientación en Microbiología Médica.
Maestría en Ciencias
Doctorado en Ciencias

Investigación
Te invitamos a que consultes las líneas de investigación desarrollas en el Departamento de Microbiología